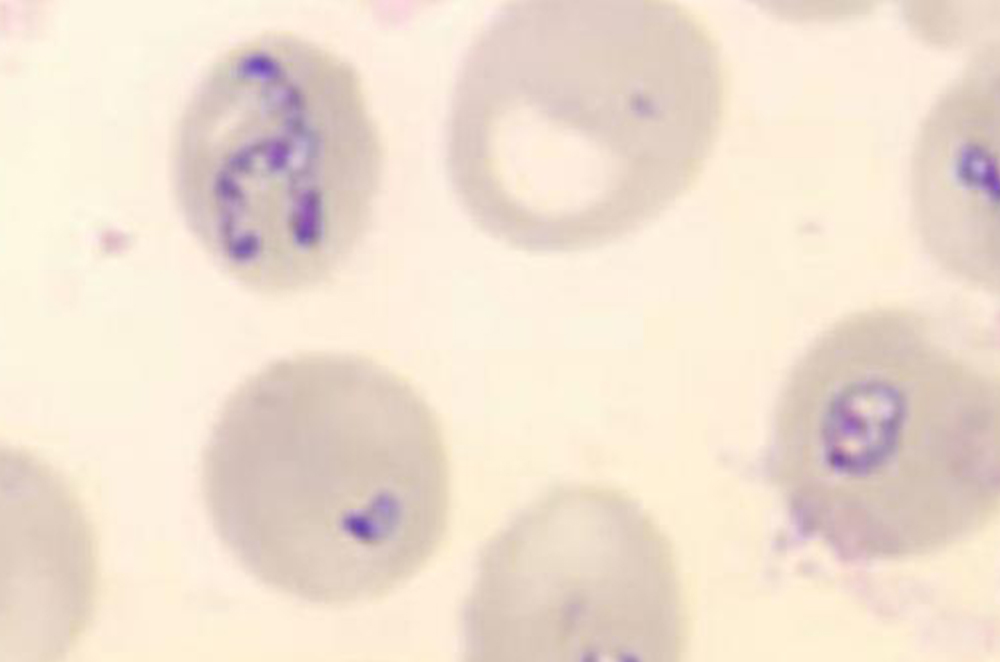
Babeszjoza

Faktem jest, że kleszcze mogą zawierać wiele patogenów oraz przenosić równie wiele chorób. Poniżej znajduje się opis patogenów, którymi oprócz wirusa KZM i bakterii Borrelia, może zarazić cię kleszcz.

Riketsjozy to choroby zwierząt i ludzi wywołane przez grupę bakterii należących do riketsji, są one: gram ujemne G (-), obligatoryjnie wewnątrzkomórkowe, nie posiadają ściany komórkowej, gdyż nie produkują lipopolisacharydów (LPS) i glikopeptydów, wymagają transmisji poprzez wektor.
Zakażenia ludzi wywołane przez te bakterie nie są tak powszechne jak borelioza, ich transmisja jest mniej intensywna.

Anaplazmoza – jest to ostra choroba gorączkowa. Zajmuje leukocyty i komórki śródbłonka. Groźna dla osób z osłabioną odpornością, prowadzącą do ciężkiego przebiegu choroby. Okres wylęgania wynosi ok. 9 dni. Pojawia się gorączka o nagłym początku z bólem głowy, dreszczami, złym samopoczuciem i bólami mięśni. Mogą one być bardzo dotkliwe. Rzadziej występuje upośledzenie łaknienia, nudności, wymioty, bóle brzucha, biegunka, kaszel czy splątanie. U ok. 30% pacjentów w Europie współistnieją one z kleszczowym zapaleniem mózgu lub boreliozą z Lyme. Najczęściej dochodzi do wyleczenia, nawet bez stosowania właściwej antybiotykoterapii.

Ostra, bakteryjna choroba gorączkowa. Jak dotąd nie rozpoznano tego zakażenia u ludzi w Europie. Najczęściej jest to gorączka o nagłym początku z silnym bólem głowy, dreszczami, złym samopoczuciem oraz wysypką (występuje u ok. 40% chorych, jednak u jedynie 6% na początku choroby). Wysypka ma charakter najczęściej plamisty lub plamisto-grudkowy, czasem krwotoczny i zwykle obejmuje tułów i kończyny. Okres wylęgania wynosi 7-10 dni. Zakażenie E. chaffeensis może być bezobjawowe, jak też mieć bardzo ciężki przebieg. Średnio choroba trwa 23 dni. Najczęściej dochodzi do wyleczenia, nawet bez stosowania właściwej antybiotykoterapii.
Gorączka Q
Gorączka Q jest zoonozą, czyli chorobą, która może przenosić się ze zwierząt na ludzi. Kleszcz, żerując na zakażonym zwierzęciu, wraz z odchodami pozostawia na skórze, sierści, wełnie patogeny, które szybko wysychając, stanowią składnik pyłu i kurzu na sierści zwierząt żywych, jak i produktów pochodzących od zakażonych zwierząt. Do zakażenia u ludzi może dochodzić głównie przez wdychanie skażonego aerozolu.
Kozia grypa jest to nazwa potoczna nadana przez media zachorowaniom na Gorączkę Q występującym od roku 2007 w Holandii.
Rickettsia slovakia i Rickettsia raoultii (TIBOLA/DEBONEL)
Rickettsja slovakia i
Rickettsia raoultii odpowiadają za TIBOLA – Tick-Borne Lymphadenitis, nazywana w Hiszpanii również DEBONEL, od Dermacentor-Borne Necrosis – Erythema Lymphadenopathy. Nowa propozycja nazwania tej choroby to SENLAT -Scalp Eschar and Neck Lymph Adenopathy. TIBOLA jest riketsjozą opisaną po raz pierwszy we Francji. Opisano przypadki jej występowania w Hiszpanii, Portugalii, na Węgrzech, w Austrii, Słowacji, Słowenii, Rumunii, Chorwacji, Bułgarii i w Polsce.
Zakaża kleszcz
Dermacentor reticulatus, który stosunkowo rzadko atakuje ludzi, częściej psy. Jego aktywność wyprzedza wiosną
I. ricinus, rozpoczyna żerowanie już w maju. Ukłucie kleszcza powoduje powstanie strupa na głowie i odczynowego powiększenia węzłów chłonnych.
Bartonelloza
Bartonella spp. to bakterie wewnątrzkomórkowe, wykazujące powinowactwo do erytrocytów oraz komórek nabłonka naczyń krwionośnych. Bakterie przenoszone są przez pchły, wszy, a także kleszcze, które żywią się krwią zakażonych ssaków i wykazują ścisłą preferencję przenoszonego gatunku bakterii, jak i rezerwuaru. Odnaleziono obecność
B. henselae w kleszczach, jednak jak dotąd nie opisano przypadku zachorowania po pokłuciu przez kleszcze w Polsce.

Krymsko-kongijska gorączka krwotoczna (CCHF) jest chorobą wirusową przenoszoną przez kleszcze. Wywołuje ją arbowirus z rodziny Bunyaviridae. Wektorem wirusa są kleszcze z gatunku Hyalomma spp., które występują w Afryce, na Bliskim Wschodzie (od Kongo po Krym). Główną drogą zakażenia człowieka jest pokłucie przez kleszcza zarażonego wirusem. Choroba może szerzyć się także poprzez bezpośredni kontakt z krwią i płynami ustrojowymi / tkankami zakażonych ludzi. Do zakażenia może dojść także podczas kontaktu z zakażonymi zwierzętami lub skażonym mięsem, krwią czy skórą (głównie narażeni są więc myśliwi, leśnicy, turyści). W najcięższych przypadkach doprowadza do zaburzeń krzepnięcia krwi. Może to doprowadzić do krwawienia wewnętrznego, krwotoków wewnątrzjelitowych oraz do krwistych wymiotów.
Choroba ta występuje głównie w rejonie basenu Morza Śródziemnego. Typowe objawy bebeszjozy to gorączka, zmęczenie i bóle mięśniowe. Ludzi dotyka jednak rzadko, częściej występuje wśród bydła i psów. Pasożyty niszczą czerwone krwinki (erytrocyty), co może okazać się śmiertelne dla zwierzęcia. Choroba wywołuje u zwierząt podobne objawy jak malaria u ludzi, dlatego też w Europie określa się ją czasem mianem „psiej malarii”. Za przenoszenie babeszji w Europie jest głównie odpowiedzialny kleszcz Dermacentor.

Kleszczowe zapalenie mózgu (KZM) jest chorobą powodowaną przez wirus KZM objawiającą się zapaleniem opon mózgowo-rdzeniowych, zapaleniem mózgu lub jednym i drugim. Może być śmiertelne.

Borelioza jest chorobą zakaźną powodowaną przez bakterię Borrelia burgdorferi. Bakteria ta może zaatakować skórę, układ nerwowy, stawy, serce, narząd wzroku. (Zajkowska J. Objawy oraz leczenie najczęstszych postaci boreliozy z Lyme.W:Vademecum wybranych chorób odzwierzęcych w środowisku leśnym. Poznań 2012)


Zobacz, czy jesteś w grupie ryzyka zakażenia się kleszczowym zapaleniem mózgu.
Zrób test